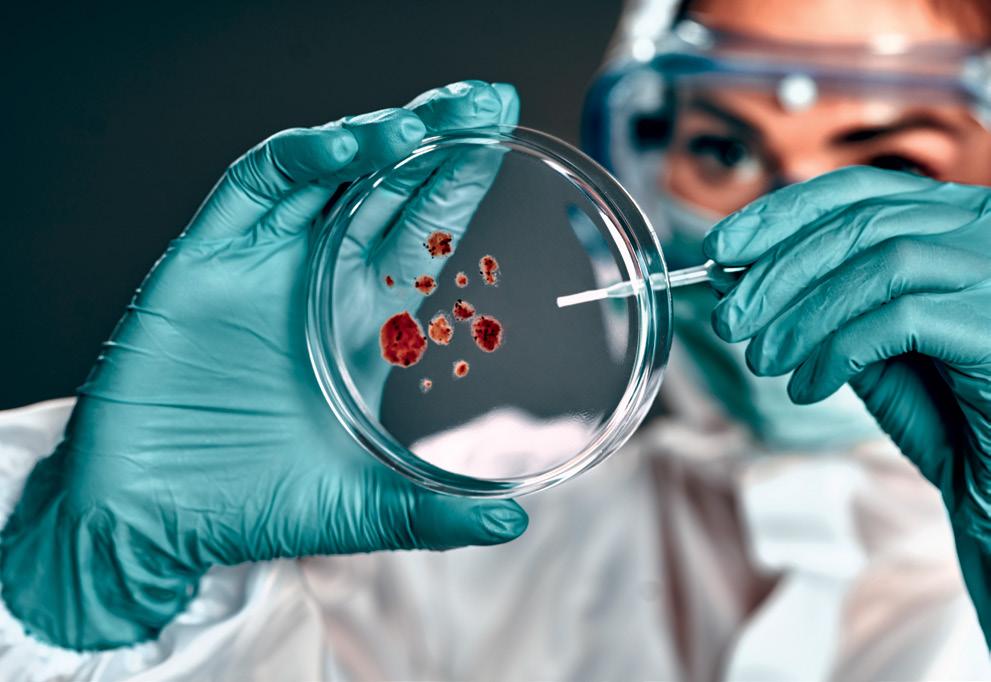

CAREERS TECHNOLOGY





Think healthy oceans are just good for the fish? In fact, covering 70% of the planet, they are one of the keys to ongoing human survival. Yet many oceans and their marine life are under threat by human activity.

Macquarie’s degrees in Science, Environment and Engineering offer diverse majors to prepare you to tackle the problems and threats facing the world’s oceans. Study at the university ranked number 1 in the world for the UN Sustainable Development Goal Number 14: Life Below Water.

Or set yourself apart with an interdisciplinary double degree, combining a Bachelor of Science with our Bachelor of Environment or Bachelor of Engineering and get ready for a rewarding career which not only feeds your curiosity, but makes a concrete difference solving marine conservation issues.
FIND OUT MORE AND APPLY TODAY.

The next tech revolution will need people with all sorts of skills and interests
Since working at Google, I’ve learnt that 15 years in tech is a really long time – it’s just one revolution after another!
Now, we have the AI revolution and it will have large implications for future jobs and the skill sets people will need.
I haven’t used the technical skills I learnt at uni in many years. The most important uni lesson was learning to learn and be adaptable, and that’s what a STEM degree will teach you. And you’ll need to be prepared to acquire new technical skills as the technology evolves.
One area of my job that has remained constant is managing teams. To my surprise, I have very much enjoyed helping people navigate changes and make decisions. For students, my advice is to be open to new career paths and roles. Your career can pivot in many different directions throughout your life; it’s normal to change careers many times, especially given the world around us is changing all the time.
careers many times”
Everyone is welcome in STEM – more than ever we need people with different skills and backgrounds working together to solve the big problems we’re facing. I’m lucky enough to work with people from all different specialities and interests, from ethics and anthropology to medicine and electrical engineering. Each of them brings a unique perspective to the team and how they work together. As we enter this new technological era, I want everyone to know that there’s a place for them if they want it.
Grace Chung Head of Research, Site Lead and Engineering Director, Google Australia

We reconnect with past cover stars and look forward to the coming 10 years of tech careers
P6 Where are they now? Meet the Googlers staying the STEM course
P12
P8 Cool tech places to work… in Australia and New Zealand

P10 Hey Google, tell me about careers Meet the next generation of tech stars
P12 All you need to know about AI… and the jobs it will create

P14 10 career changing technologies From new to mainstream in the blink of an eye
Everywhere
STEM + X = Combine technology (STEM) with your passion (+ X) to discover your dream career…
Technology + …
P22 Tech + AI & Robotics
Humans + AI = new careers
P26 Tech + Cyber Security
Wanted: digital superheroes to safeguard our data and online lives!


P30 Tech + Oceans
Love the ocean? Get ready for these careers launching from a boat ramp near you

P34 Tech + Business
How today’s tech is transforming tomorrow’s business world and the skills you’ll need for it

P38 Tech + Health
Join the health-tech community transforming healthcare
around us, tech is on the cusp of new breakthroughs – think AI that creates images and text, telescopes that can capture never-before seen images of the universe and quantum computers that will solve even the most complex of problems. All of these evolutions in tech, and many others, will require highly skilled graduates. There are many paths to a successful career in tech and, now more than ever, the tech sector needs people with varied interests and backgrounds. No matter your personal interests, chances are there’s a tech role out there for you combining your passion with tech skills for a rewarding and successful career.P14 P38 P30
Artistic and digitally savvy? Find your artstech career here

Inspired by first responders? Disasters also need tech workers behind the scenes

P49 Quiz: should I teach myself to code?
In 2014, most young people had stereotyped ideas about the hoodie-wearing tech guy, and less than 2% of students were graduating computer science. It was also the year the very first edition of Careers with Code magazine was released, with Google as a founding sponsor.
We packed the magazine with stories of how people really worked in tech – like the Googlers on this page (see what they’re up to now on page 6). And like product manager Ganesh Shankar, who worked with doctors to help safely share patient data during 2014’s large Ebola outbreak.
In that first issue, we created the concept of STEM + X (where ‘X’ stands for your passion or goal), and focused on busting stereotypes. We featured the founders of Atlassian, the software engineers behind ‘design-your-own’ shoe fashion, and programmers working on marine sonar technology.
In 2015, Careers with Code went to the US and Aotearoa New Zealand, and in 2016 it was promoted by then US president Barack Obama. In 10 years, we’ve distributed 2 million free
magazines to high schools across the globe, and created special issues on everything from quantum technologies to space, defence, and even digital retail.
We’ve made 26 Job Kits based on careers like metaverse engineer, game designer, and software developer (we still need them!). Through events, mags, websites and newsletters, we’ve reached well over 4 million people.

With mega advances in AI and data, we need to ensure equitable development of technology, with more women, people of colour, people with disabilities and First Nations people choosing tech careers. Enrolment rates for women in IT degrees have increased from 13% to 18% in the five years from 2015 to 2020. There’s still a long way to go, and so much inspiration that you’ll find in this 10th issue. Make sure you also check out CareerswithSTEM.com to find your ‘X’, plus quizzes and videos to help you find a career in tech, whatever your interests are. –
 Heather Catchpole & Karen Taylor-Brown
Heather Catchpole & Karen Taylor-Brown

Ever wonder what career you’ll have in 10 years? Take it from these Googlers: it could be very different to what you imagine!
We caught up with some of the stars of Careers with STEM from years past to find out why they still love STEM and some lessons they’ve learnt along the way.
SaraIn 2010, Sara was studying environmental science at university when she took some elective units in computer science. Sara loved the classes so much she decided to switch her major to computing and mathematical science, and in her honours year landed a gig working as a software engineer for Google Maps.
In her 10 years at Google, Sara says she has been constantly learning and growing from working with different technologies and different products.

“I love that software engineering is highly technical, but also involves so much relationship building and working with people, which is a perfect match for my skills,” Sara says. “I would never have expected to be where I am now. And I see many graduates who are like I was, and it’s exciting to know they can get there too!”
“I’ve learnt that embracing change and unknowns is a skill in itself and every time you have to do it again you do it a bit better.”
“With how quickly tech changes things, it makes it especially important to invest in building your networks – when new opportunities come up, people in your network will think of you for those roles.”
In 2015, Dominick was juggling a PhD and work as an analyst wrangling data for Sydney Uni. He decided to step away from academia and experience life in the tech sector. In his current gig, Dominick enjoys getting creative with problem-solving. “You usually can’t just recycle old ideas, instead you have to take inspiration from them to come up with new ideas to address new problems,” he says. A recent highlight was sharing his work at Google’s big annual developer conference. “Engineers don’t often get to do these presentations, so it was awesome to see firsthand the impact our work has for so many people around the world,” Dominick says.
“The only constant is that change will happen, so you have to expect it and be ready for it.”
In 2017, Gabie was in her second year of a software engineering degree when she landed a coveted summer internship placement with Google.
Now a full-time software engineer with the company, Gabie says she loves being able to build products that take into account people’s different needs and preferences.

“For example, I’ve loved working on bringing a handwriting app to ChromeOS for those who prefer writing over typing. It was something I always wished I had as a student, and now I get to be a part of making that possible.”
“You will see many changes in the tech landscape as you’re looking for job opportunities. So, use the time in your studies to learn how to learn skills in your area. This can be things like learning which questions to ask, or identifying high-level processes for problem-solving.”
Graduating from UNSW in 2010 with a degree in bioinformatics (engineering), Amy realised the computing part of her job could open a lot of other doors, not just in biology. She started her full-time career in a finance firm, a choice which led to her current career at Google.
In her role as tech lead manager, Amy says there are always new problems to solve. “Most of these problems aren’t easy and I think what keeps me going is the satisfaction of being able to say I solved that one… and another one pops up that looks interesting,” Amy says.
During her almost 10 years at Google, Amy was surprised to find herself a manager of people. “I see coding as one way to solve a problem. Over the years I’ve solved some by just simply talking to people. And now, understanding how people work and how to help them is simply a different type of problem to solve,” she says.
“I’ve come to find a lot of satisfaction with helping folks with their ‘aha’ moment that helps them to the next step in their career.”
“There are always new ideas and new trends that’ll come up, but it’s important to remember that all of these changes just mean more interesting and different problems for you to solve!”
There are so many awesome tech companies to work for in Australia and Aotearoa New Zealand. We’ve chosen 10 to tell you about and have highlighted how they fit into your very own STEM + X – where ‘X’ is your passion, an interest, another subject, a big opportunity or a life-changing goal. – Louise
Thousands of Googlers work at Google Sydney, which is also the birthplace of Google Maps and the Go programming language! At this tech mecca, you could score a role in anything from security for Google Cloud to testing wearables and ensuring site reliability.
X areas: AI, creativity, cyber security, quantum

This online graphic design tool lets you create social media graphics, presentations, invitations and more. You could work in technical business analytics, data privacy, user experience or frontend and backend development.
X areas: Creativity, design, education
2 3 4 5

This iconic Australian company powers our phone calls and internet through its massive telecommunications network. Telstra needs lots of people with cutting-edge skills in data, cloud and software engineering and network technology – so there could be a place here for you after studying telecommunications or IT at TAFE, or computer science at uni.
X areas: Communications, cyber security

Think of these guys as the tech company for tech people!
Atlassian builds products and tools that software developers, IT experts and project managers use to make their jobs easier. The Australian base is in Sydney, but there are offices all over the world and the company has a great work from home policy!
X areas: AI, design

As Australia’s largest bank, the Commonwealth Bank employs hundreds of graduates each year. It’s big on tech too, with large teams working in engineering, data analytics, AI and cyber security on cutting-edge projects. Hear what this gig is like from a CommBank technology graduate at bit.ly/3NIB51V
X areas: Finance, AI

Xero provides cloud accounting software for businesses and they have over 3 million subscribers worldwide! Their HQ is in Wellington and they pride themselves on being an authentic, inclusive and sustainable employer. They also have brilliant graduate and internship programs to help you get your foot in the door.
X areas: Business, finance
This Kiwi company is all about the future of farming. It designs ergonomic smart collars for cows that run on solar power. The collars are paired with an app, which allows humans to give signals to cows. The app also translates animal behaviour into data and insights! Epic stuff.
X areas: Animals, environment
Based in Auckland, Ambit is an AI platform that turns your content and data into human-like conversations. It’s essentially a super smart chatbot that’s a pro at customer service in industries like retail, energy and finance. Ambit is one to watch if you’re interested in machine learning or software engineering.


X areas: AI, business, resources and energy, retail
If you want to mix music with tech to create your dream career, apply for a job at Serato! It makes audio software that’s used by millions of DJs, producers, engineers and musicians. Serato is always on the lookout for DJs, designers, developers, mix-masters and marketers to join its Auckland team.

X area: Creativity
Cogo creates products that help small businesses, banks and individuals measure, reduce and offset their impact on the environment. It’s also on a mission to be the world’s first gigacorn – a company that can cut one gigaton (one billion tonnes) of carbon from the atmosphere each year while still making money!
X area: Environment

We asked three Googlers how they landed their amazing tech jobs! #1

Candice is a proud Indigenous Australian woman: she is Larrakia and Wadjigan from her father’s side and Arabunna from her mother’s side. Before landing her current role at Google, Candice completed a Bachelor of Computer Science at RMIT, a cyber security internship at Westpac and worked in a couple of different security and software roles.

Now, as a blue team security engineer, it’s her job to detect cyber security threats to Google.
“A fun part of my job is being able to engineer new detections to be deployed across the fleet,” Candice says.
What does she enjoy most about her job?
Writing code, identifying the tactics, techniques and procedures involved after analysing how a threat actor (that’s someone who wants to cause harm in the cyber realm) may operate, and what’s required to detect and mitigate these types of attacks.

Candice believes the cyber security industry is growing, leading to more jobs for new grads.
“There are now more pathways to cyber security. University is one path, but there are numerous quality short and free online courses, tutorials and security blogs, as well as industry accredited certifications,” she says.
Google proudly advertises that it doesn’t care whether or not you have a degree: what matters is that you’re skilled and nice to work with.
It’s Candice Bowditch’s job to keep Google systems safe from hackers and other cyber security threats

Max’s love of maths, physics and geography led him to a Bachelor of Science specialising in computer science and maths at the University of Canterbury. He then interned for Google Photos, before locking in a full-time gig in Google’s Cloud Firestore team as a site reliability engineer. Every day at work is different for Max. Some days he’s on call for a Google service and responding to issues as they arise, and some days he’s working to improve the reliability of future features. And others? “I’m waist deep in various configuration files to understand how the pieces all fit together to bring everything to our users seamlessly!”

He loves working at Google and says the scale of the company continues to blow his mind. “At the click of a button, I can ask for more resources than I would have thought possible,” he explains.
If he could go back and give his younger self some advice, he’d say to consider taking the ‘risky option’. “Be willing to try things you aren’t sure you’ll like. You can always fall back to a ‘safer’ path that you know you enjoy later.”
WhenAnna decided to combine computer science and accounting at uni it proved to be a winning move. “I wasn’t sure how an accounting degree would help me as a software engineer, but understanding the business side and the ‘why’ aspect of problems has landed me jobs and made me a better programmer,” she says.
While at uni, Anna interned for tech companies GBST and Atlassian before moving to Sydney to take up a graduate software engineering position at Google.

In her role, Anna helps keep Google users safe by verifying identities. “It’s my team’s job to make sure our users are who they say they are,” she says.
A typical day for Anna starts by collecting feedback from users. She takes this info to product managers and her team to identify what work they should do. With her team, she designs, builds and tests the solution, then ships it to the users and confirms that it meets their needs.
Anna’s advice for high school students is to keep an open mind about careers and follow your passions. “You’ll be surprised by how seemingly random interests and paths will open doors to opportunities that you never thought were possible.” —
Louise Meers Anna Truffet works to verify user identities to prevent financial crime Max Griffiths uses his computer science skills to keep Google products running smoothly and reliablySo here’s everything you need to know!
From ChatGPT and voice assistants, to facial recognition and self-driving cars, the world can’t stop talking about – and using – AI. Don’t really get what all the hype is about? Then this is for you. We’ll get you up to speed on what AI is, what it’s capable of, the pros, the cons and the AI careers of the future you could be a part of.


AI is already a huge part of our lives. It’s there when you unlock your phone with your face, ask Google Maps for the quickest route to the place you’re going and when you open ChatGPT to brainstorm assignment ideas. It’s also being used in a range of industries: in banking it’s a good tool for detecting fraud, in healthcare it can scan large amounts of data to make better diagnoses and in transportation it can alter traffic light algorithms to manage roads in real time.
• Conservation
• Education
• Farming
• Finance
• Healthcare
• Manufacturing
• Retail
• Transportation
AI is all about developing computer systems that use big data sets to solve problems and perform ‘intelligent’ tasks. These include things like visual perception, reasoning and decision-making, and understanding natural language. One of the ways to build these systems is through machine learning. It gives the computer examples of what it should do, then lets it figure out how to do it.
Is trust! A University of Queensland and KPMG Australia study found that only 40% of Australians trust the use of AI at work. This stems from ethical concerns like bias and discrimination, data privacy and regulation. Workers are also worried about where they fit into the AI workplace: a Microsoft survey revealed that 49% of people worry about AI replacing their jobs.


AI can save time, analyse massive amounts of data for smarter decisions and minimise human errors. These positives are felt in everyday life and across all sorts of industries. Did you know that 89% of large businesses in Australia are already using AI technology? It’s something that’s here to stay and set to grow, so keep it in mind as you consider uni and TAFE courses and your future electives.

Regardless of your feelings about AI, one thing is for sure: it will create heaps of workforce change. The 100 Jobs of the Future report identified potential new and surprising roles, some of which don’t even exist yet. Below are ones in AI to look out for!
Someone who teaches others how to get the most out of AI. This could include things like working with household robots, digital assistants or using big data to make decisions.
A next level patent lawyer! These STEM pros will negotiate on behalf of AI entities that have created new things. They’ll also represent humans when AI has used their ideas without permission.
Someone who can help when your self-driving car gets hacked, experiences unexpected extreme weather or can’t work out what to do with the human-driven car in front of it that’s breaking the road rules!
Who you’ll call when AI gets it wrong. This kind of analyst will tweak the algorithm so you get a better solution, and will identify the data inputs that led to the incorrect result.
Keen on AI? Check out our free Machine Learning Engineer job kit by scanning here!
Electric cars, video calls and even affordable rocket launchers are all technologies that were once futuristic but are now changing how we live – and creating new gigs in STEM. Some say the next decade might be the most transformational ever for tech, as AI, remote work and data begin to change how we do our jobs. So, which technologies will be the next big thing in 2033 and how will they change STEM careers forever?
– Rachel WilliamsonCurrent computing is reaching its limits but researchers hope quantum computers, which make decisions by using the probability of, say, which direction an electron is spinning, might be the next step. It won’t mean you need a PhD to design computers, but you will need to learn how to code for a very different system of computing. Quantum is set to change every part of life, from medicine to finance and cyber security.
By the 2030s, we should have found some interesting ways to use AI in all sorts of different sectors. It could be nurses managing hundreds of patients simultaneously thanks to AI that flags minor changes in their conditions, or biochemists picking that one molecule from millions that can cure cancer. And instead of coding, the new ‘it’ skills will be creativity, critical thinking and complex information processing.

Air travel makes up about 2.5% of the world’s CO2 emissions but finding an e-fuel (a sustainable alternative to fossil fuel) that can keep planes in the sky for long periods of time?
Tricky. That’s why we’ll need chemical and process engineers who can create and build the fuels and engines of the future.
The Moon could be the next agricultural frontier as NASA gears up for the Artemis III moon landing in 2025 – the first in over 50 years. RMIT is planning to send seedlings to the Moon, as is the European Space Agency and a Norwegian company called Solys Mining, to test how plants grow in extreme environments. If humans can grow food on the Moon, it might mean more time in space for scientists and the new world of space workers. It could also change the way agritech researchers look at Earth’s environment as it gets more extreme.

And while up there, space miners might be able to shoot moon dust into Earth’s atmosphere to block out the sun’s rays. Climate geoengineering is planet-wide carbon dioxide removal and solar radiation management and it’s a fraught subject because we don’t fully understand the potential ramifications of tweaking the atmosphere. If this industry gets underway, it’ll spawn a whole new wave of STEM careers in atmospheric sciences.

Precision medicine combines genomics, big data analytics and population-level health data. It will allow scientists and doctors to take health to a new level, predicting disease risk and giving patients customised treatments. But with so much personal data floating around, it’ll require a new look at how health does cyber security.

The next step in health is the development of designer viruses that infect different bacteria with new genetic information in order to improve human and plant health.
Scientists are already coming up with new ways to make nitrates from plasma and even engineering plants that can make their own fertiliser.
Neural electronics will allow us to use our brain to communicate directly with electronics, rather than using our voice or touch.
A ‘longevity industry’ is emerging that seeks to delay death for as long as possible.
TAFEs around Australia have been given government funding for hundreds of qualifications, from certificates to diplomas, all on offer at no cost for priority groups and sectors. And guess what? Tech and young people aged 17 to 24 are big priorities!

A TAFE qualification could help you transition from school to uni, or it could get you the entry-level position you need to kickstart your dream career.
Support existing tech or apps, provide tech support or build basic apps.
Free courses:
Certificate IV in Information Technology
(Programming) (NSW)
Certificate III in Information Technology
(VIC) (NSW) (QLD) (WA)
Diploma of Applied Blockchain (QLD)
Diploma of Information Technology
(Advanced Programming) (QLD) (WA)
Build animations for company presentations or digital design agencies.
Free courses:
Certificate III in Information Technology
(VIC) (NSW) (QLD)
Analyse data to help protect organisations against cyber security breaches and attacks.
Free courses:
Certificate IV in Cyber Security (NSW)
(VIC) (QLD)
Certificate III in Information Technology
(VIC) (NSW) (QLD) (WA)
Advanced Diploma of Cyber Security (WA)
Certificate IV in Information Technology
(Cyber Security Incident Response) (WA)
Work with big databases to help people make data-informed decisions.
Free courses:
Diploma of Information Technology
(Database and Data Management) (NSW)
Certificate III in Information Technology
(VIC) (NSW) (QLD) (WA)
Test or develop games or assist with game animation.
Free courses:
Certificate IV in Information Technology
(Gaming Development) (NSW)
Diploma of Information Technology
(Game Art and Design) (NSW)
Diploma of Information Technology
(Game Programming) (NSW)
Diploma of Screen and Media - Animation, Gaming and Visual Effects (QLD)
Diploma of Information Technology
(Games and Intelligent Systems) (WA)
Combine IT with business strategy or project management.
Free courses:
Advanced Diploma of Information Technology (IT Strategy and Organisational Development) (NSW)
Certificate III in Information Technology
(VIC) (NSW) (QLD) (WA)
Join the IT crowd and provide technical support to customers and employees!
Free courses:
Certificate III in Information Technology
( VIC) (NSW ) (QLD) ( WA)
Certificate IV in Information Technology
(Systems Administration Support) (NSW)
Set up the servers or cloud computing infrastructure that organisations run on and help maintain it.
Free courses:
Certificate IV in Information Technology
(Networking ) (NSW )
Diploma of Information Technology
(Advanced Networking and Systems Administration) (QLD) ( WA)
Certificate IV in Computer Systems ( WA)
Work with mobile phone or internet infrastructure to fix customer problems.
Free courses:
Certificate III in Telecommunications Technology ( Telecommunications Cabling ) (NSW )
Build websites or provide website support to web design companies.
Free courses:
Certificate IV in Information Technology
( Web Development) (NSW )
Diploma of Information Technology
(Back End Web Development) & (Front End Web Development) (QLD) (WA) (NSW)
Your career can take a variety of twists and turns, steps and stages. yourcareer.gov.au can help you make informed decisions about your learning, training and career development.

“Seek out volunteer opportunities. It might be restoring a stream, tracking bats, helping create dark sky reserves or doing online citizen science.”
Dr Victoria Metcalf, scientist and science communicator
They’re doing everything from advising governments to making Netflix series, so if you’re thinking about a career in STEM, these women know how to get there – Rachel Williamson


“Find an organisation that’s flexible and really values what you do.”
Dr Sarah Pearce, SKA Low Telescope director, SKA Observatory
“Follow your passion and curiosity for all things science as that is the most important quality to succeed.”
Emily Calandrelli, science communicator / Netflix producer


“Your wildest dreams can’t predict the opportunities that will arise from putting yourself out there and trying something new.”
“Find people that inspire you and ask them how they got to where they are now. People love to share their stories, especially with young, enthusiastic minds.”
“There are so many resources and programs out there for people wanting to learn… don’t be afraid to have a go!”
Brooke Jamieson, senior developer advocate, Amazon Web Services
“Having some basic programming knowledge can improve scientific workflow and analysis, and open doors to using new methods or techniques.”
Dr KirstinDeuss, soil scientist, Manaaki Whenua
Dr Kira Rundel, commercial manager, RayGenDr Lauren Vargo, research fellow, Victoria University of Wellington


People with quality coding skills are always in hot demand, but what if there was a tech tool to help you code without having to learn a programming language? Talk about meta!
That’s what the no-code movement is all about. No-code platforms offer simple drag-and-drop tools to enable people without coding skills to build websites, apps and other digital creations. It’s sort of like being given building blocks rather than having to construct the whole building from scratch. For Elizabeth Knight, an entrepreneur who started her first business at 19, no-code has allowed her to turn her ideas into reality without needing lots of money or tech skills.
The

“I hope it will shift power away from patriarchal institutions in the business world, and give power back to founders and creators,” Elizabeth says.
When she first started her business career in a co-working space, Elizabeth says she was surrounded by “a lot of guys in their 20s who fit the tech/startup bro stereotype,” having conversations about tech that seemed exclusive and inaccessible.
Having used no-code to help build the tech her business needed, she hasn’t looked back. “Finally I felt legitimised in the tech scene,” Elizabeth says.
She’s now running a business teaching others how to use no-code! – Charis Palmer

I hope it will give power back to founders”
Wondering how a STEM job fits with your everyday interests? We’ve got just the formula to work it out!
Careers with STEM’s secret formula is all about combining STEM (science, technology, engineering and/or maths) with ‘X’ – your other passion, hobby, interest or goal.

Over the following pages, we’ve highlighted people and pathways combining technology with business, creativity, cyber security, disaster response, health, AI & robotics and oceans. On this page are just some of the Xs you could explore to find your dream job!




Did you know you can search for STEM role models and career mentors on our website by their ‘X’? Find people combining their technology skills with their passion for wildlife, maths pros working in the creative sector, engineers exploring space, and more – and get inspired about what your future career might look like!

CareerswithSTEM.com/ stem-x-role-models
Not sure where to start? Take our STEM+X quiz!

AI is so hot right now, but where do humans fit in? Here are some super inspiring stories in which humans + AI = big wins
From helping farmers improve crops, to protecting threatened species and marine life, AI is the new tech tool STEM workers are turning to.
It’s easy to think of AI as robotic and perhaps a little cold, but in the right hands it can turn humans into superheroes!
AI is even being used to help protect workers from being exploited – check out Adriana Bora’s profile on page 25 to learn how. Collabs between AI and humans are creating new careers. Here are a few projects to spark your imagination about a career in AI & robotics… – Charis Palmer
Did you know that researchers, using sensors all over Australia, have recorded more than 17 million hours of raw audio?
Some of that audio includes bird sounds, but imagine trying to isolate one species in that giant haystack of data! AI + humans to the rescue…
Scientists at QUT, including computer science Professor Paul Roe and ecologist Dr Daniella Teixeira have collaborated with Google on an AI solution that isolates the specific sound of the threatened Glossy Black Cockatoo. Armed with more information on where the cockatoos are and where they might be becoming less vocal, they can get on with the work needed to protect them. They’re also looking to use the same AI tool to identify other threatened species like koalas, as well as species we want less of, like cane toads and Indian myna birds.


TECHNOLOGY + AI & ROBOTICS + STUDY
Bachelor of Artificial Intelligence, Deakin University
Bachelor of Information Technology ( Artificial Intelligence), Macquarie University
Bachelor of Science (Artificial Intelligence)
Victoria University of Wellington
Bachelor of Computer Science (Artificial Intelligence), The University of Adelaide
Bachelor of Computer Science (AI and Big Data), University of Wollongong

TECHNOLOGY + AI & ROBOTICS + JOBS
Automation engineer $57K–$120K / NZ$55K–NZ$102K
Machine learning engineer $57K–$130K / NZ$51K–NZ$127K
Scientific researcher $58K–$125K / NZ$51K–NZ$99K

Software engineer $57K–$118K / NZ$56K–NZ$111K*
*Salaries according to payscale.com
Mahla Nejati’s early love of programming came from robotics competitions at school and now she loves solving real-world problems with algorithms
When Mahla was a child watching her dad teach science, she always figured she’d end up being a chemist.
“I was seeing and reading all of my dad’s books and I was fascinated by the drawings of equipment in the labs,” Mahla says.
But after joining a robotics competition and learning some programming at high school, Mahla realised she was good at software engineering – and that has driven her career ever since.
“It was a soccer robotics competition where I learnt programming languages like C and C++. And I’d already been playing around with HTML and PHP,” Mahla says.
Today, Mahla is programming some seriously advanced robots using AI in the agriculture sector to help improve crops.

“At uni I loved learning about algorithms because it meant solving real-world problems with maths,” she says. Her expertise is image processing: teaching robots to recognise things using AI, like the fact they’re picking a kiwi fruit as opposed to an apple. Mahla says programming AI is like teaching a baby to walk.
“It’s really interesting because it’s not abstract. You do some coding and straight away you see the results,” Mahla says.
Her work means she gets to tackle big challenges alongside other engineers, including mechanical and electrical, and also with the help of biologists who understand how different crops thrive.
Mahla’s advice to students considering a career in technology is to try a lot of things: “I thought I was going to be better in another major, but because I tried other things early on I realised what I was good at and was able to spend more time on those things. Just trust yourself and give it a try.” –
Bachelor of Computer Software Engineering, Ferdowsi University of Mashhad Master of Artificial Intelligence, Ferdowsi University of Mashhad Teaching assistant, Ferdowsi University of Mashhad Head graduate teaching assistant, University of Auckland Research fellow, University of Auckland PhD in Computer Systems Engineering, University of Auckland Charis Palmer mahlaresearchnejati fellowJust trust yourself and give it a try”
Mixing AI with social good has proven to be a winning combo for Adriana Bora, who is using her tech skills to fight modern slavery
Adriana once had her sights set on studying STEM. But after doing volunteer work and getting involved in student unions, her perspective changed.
“I had that first touch with policy and I realised there was so much I didn’t understand because I was just so focused on my maths, computer science and physics.”
Adriana switched up her plans to study computer science and enrolled in a Bachelor of Arts majoring in international relations and advanced quantitative methods instead. It was during an exchange to Hong Kong that she became aware of the issue of modern slavery. Once she started studying it, she couldn’t stop. “I thought: ‘how can I bring my learnings about stats and political science into the fight against this crime?’”
She went on to do a thesis using data science to understand modern slavery, then a Master of International Public Management. During her master’s, Adriana realised that AI could be used to help unearth more evidence in the fight against modern slavery.

She built a prototype for Project AIMS (AI against Modern Slavery) that uses machine learning to analyse what businesses are saying they are doing to tackle slavery in their supply chain. Adriana then scaled the project as part of The Future Society and Walk Free Foundation, and received the UNESCO IRCAI AI Award in 2021.

Now a PhD candidate at the QUT Centre for Data Science and the project lead as part of the Mila AI for Humanity team, Adriana is continuing to analyse modern slavery statements from Australia. Her advice for students? “Stay curious and put in the work. When opportunities come, you have to be ready to make the most of them. But make sure to take care of your mental and physical health.” –
Louise Meers Master of International Public Management, SciencesPo Paris School of International Affairs AI policy researcher and project manager, The Future Society Bachelor of Arts (International Relations and Advanced Quantitative Methods), University of Essex PhD in artificial intelligence, QUT Project lead, Mila adriana bora phd candidate SHUTTERSTOCKWhen opportunities come, you have to be ready to make the most of them”
Become a digital superhero and safeguard our data and online lives!

The 2022 Optus hack, reported to have cost the company a jaw-dropping $140 million and thousands of customers, is an unsettling reminder of the dangers of cyber crime. A constant threat in our digital world, cyber crime is one of the fastest growing forms of crime. It can cause major financial losses and expose personal information like identity documents and medical records – pretty stressful all round! That’s where cyber security experts step in: they’re fighting to safeguard our personal information.
As a cyber security professional, you’ll protect computer systems, networks and data from threats like hackers and viruses. Your day might include investigating security alerts and suspicious activity. You’ll implement firewalls and encryption to keep sensitive information safe. And one of the coolest parts of the job?
To be successful in cyber security, you’ll need a passion for staying up-to-date with the latest tech trends and a mix of skills such as these:
• Technical know-how with computers, networks and programming languages
• Really good problemsolving skills
• The ability to explain complex technical concepts to managers, clients or end-users
• Curiosity and a willingness to continuously learn and adapt as technology changes and evolves
The University of Queensland is home to AusCERT, the second oldest cyber emergency response team (CERT) in the world after Carnegie Mellon University in the United States.
Trying to outsmart hackers by understanding their tactics and making computer systems more secure. From police and defence forces to airlines, banks and private cyber security consultancies, cyber security experts are needed in all sorts of Thanksorganisations.
to our ever-increasing reliance on technology, cyber security experts are in demand, making this a promising career path for those willing to help keep the digital world safe. Are you ready to join the cyber frontlines? – Danielle Lucas
SHUTTERSTOCKIn 2020, the Australian cyber security market was valued at a whopping $5.6 billion and experts predict it will grow to $7.6 billion by 2024! Here’s some exciting news: job opportunities are booming with a growth rate of 6% a year. It’s predicted that Australia will need 30,000 more cyber security professionals by 2026.

Ethical hackers, also known as penetration testers, are cyber security professionals who play the role of a hacker and ‘attack’ a computer system in order to uncover its weaknesses. Understanding hackers’ motivations and skills is a key part of cyber security and helping organisations stay one step ahead of the bad guys.

Targeted attacks pose serious threats to an organisation’s network system, potentially leading to data breaches or financial losses. To effectively handle such incidents, preparation and response strategies are crucial.
To respond promptly to cyber threats, organisations must have policies and plans in place, along with a team of technical ninjas ready to detect and address potential dangers.
Cyber security analysts play a pivotal role in identifying and confirming cyber incidents, assessing how bad they are and prioritising the response.
The impact of the incident is minimised using containment strategies to halt the effects of the cyber attack.
After the incident, an assessment is conducted and a report is developed analysing how the situation was handled and how future incidents can be prevented.
Bachelor of Science (Cyber Security), Edith Cowan University
Bachelor of Cyber Security, Macquarie University
Bachelor of Information Technology (Cybersecurity), Monash University
Bachelor of Engineering (Honours) (Cybersecurity), Victoria University of Wellington
Certificate IV in Cyber Security, TAFE NSW
Cyber security analyst $55K–$120K / NZ$53K–NZ$135K
Ethical hacker $90K–$134K / NZ$85K–NZ$105K
Cyber security engineer $65K–$149K / NZ$65K–NZ$120K Security consultant $58K–$155K / NZ$53K–NZ$135K*
*Salaries according to payscale.com
Wanting to help others for a living had Daniella Kurnia Surya considering becoming a surgeon. She then picked cyber security instead!
When Daniella realised how in demand cyber security specialists are and how the profession lined up with her goal of helping people, she decided to give it a go.

She kickstarted her tertiary studies with a Certificate III, IV and Advanced Diploma of Cyber Security at South Metropolitan TAFE. And now? She’s about to graduate from a Bachelor of Science (Cyber Security) at Edith Cowan University.
During her time at university, Daniella has learnt how to acquire and investigate electronic evidence to catch cyber criminals, perform malware analysis to understand malware behaviour so that defensive measures can be taken, and respond to cyber security incidents.

Daniella is also currently undertaking a cyber security internship at the WA Department of the Premier and

#1 Research the company beforehand, including what they do and what they value.
#2 Have a few concrete examples of when you have used a particular skill set, such as a time when you worked on a group project that demonstrates your communication and collaboration skills.
#3 Dress formally.
Cabinet. There, her team monitors and defends against cyber criminals, as well as ensuring that organisations are complying with cyber security standards and regulations.
On studying cyber security, Daniella says: “both VET and university have contributed immensely to my learning journey. The VET pathway has been extremely beneficial to prepare me for university and my future career because it equipped me with the necessary hands-on skills, while university has significantly improved my research and report writing skills.”
– Louise MeersBoth VET and university have contributed immensely to my learning journey”

Fadzayi Chiwandire moved to Australia to study cyber security at ECU after realising how much fun she could have protecting apps from hackers
Feeling pretty certain she had failed her O-Level (similar to our ATAR) in Zimbabwe, Fadzayi followed in her brother’s footsteps and started a Diploma of Graphic Design and New Media before she even got her results.
“I didn’t want to repeat school, so I put together a portfolio, went for an interview at the college that my brother was studying at and got accepted,” Fadzayi says.
In the end she did pass her O-Level, but Fadzayi was already on a path that would eventually see her flexing some serious tech muscle working as an application security consultant with one of Australia’s leading cyber security companies.
After moving to South Africa in the wake of political turmoil in Zimbabwe, Fadzayi got a job with an agency that did web design. A few years later, she was leading a team of people, later transitioning into web development and more serious coding when she began to crave a change.
While working with banks and financial technology clients, Fadzayi witnessed some troubling security incidents that sparked her interest in cyber security.

“One of the main reasons I moved to Australia was because I wanted to get a degree in cyber security,” Fadzayi says. Her choice of Edith Cowan University, with its

renowned cyber security expertise, turned out to be an excellent one. Fadzayi says ECU helped connect her with industry and to her first casual cyber security job. It was through ECU that she later won a scholarship that included an internship with global cyber security firm CyberCX, where she now works full time.
Fadzayi also hosts Perth’s first cyber security podcast and encourages students to learn more about the industry. “It’s such a diverse field that a good place to start is researching on YouTube all the different tracks.” –
CharisPalmer fadzayi applicationchiwandiresecurity consultantCyber security is such a diverse field”
In the simplest terms, oceanographers study the ocean – but to do so they use all kinds of cool tech such as sonar, satellite technology and sea robots to explore marine ecosystems.
Robot technician
In this role, you’ll be responsible for the maintenance of underwater vehicles and you’ll help navigate these machines for a range of projects, from exploring marine wildlife to collecting ocean data.
Marine technician
These tech wizards are in charge of installing, repairing and maintaining marine vehicles of all shapes and sizes, as well as installing the vehicles’ equipment.
Although this role is broad, it’s associated with conducting submersibles in the ocean, such as telepresence technology, which helps scientists view live video from a ship, and drifters, which provide researchers with information on ocean patterns in real time.

One of the first things you learn as a child is that water and electricals don’t mix, right? Well, while you should still keep your hairdryer as far from your bathtub as possible, technology can benefit our oceans in many ways, including helping us understand and explore them better, reducing sea pollution and protecting marine wildlife.
In this section, we explore different ways you can integrate your love for the oceans with technology, and all the exciting study and career opportunities that exist in this space.

There’s no better time to get involved than the present! –RavishaRajapaksha
Here are some essential qualities for a career in technology and oceans:

✔ Accuracy
✔ Observational skills
✔ Patience
✔ Empathy
✔ Creativity
There are many study pathways that integrate technology and oceans, so it might be difficult to know where to begin. Don’t be overwhelmed! The number of pathways is actually a plus – it’ll help you explore different subjects and narrow down exactly what you’re passionate about. Here are a few options…
From AI to ‘smart gardening’ (yes, even technology and gardening go together!), this broad degree will let you focus on the topics that interest you most.

Look for tech degrees with electives like ocean engineering and ocean policy and science. With a degree like that under your belt, you’ll be on your way to an ocean tech career in no time.
Did you know oceans are responsible for about 50% of the oxygen produced on the planet?!


Needless to say, they need to be protected at ALL costs, and you could be just the one to do it.
Macquarie University’s Bachelor of Biodiversity and Conservation / Bachelor of Engineering will allow you to delve into all things marine protection and technology. With subject offerings like electronic design, and systems and aquatic ecosystems, you’ll explore how underwater vehicles are designed and produced, and how they can help ocean wildlife. Or you could major in ecology and biodiversity in the Bachelor of Science (Technology) at the University of Waikato.
This degree will also give you endless study pathways! And with the Southern Ocean on its doorstep, specialising in oceonography at the University of Otago puts you right in the heart of the action. Or at Flinders University, you could do a Bachelor of Science (Ocean and Climate Sciences) to learn all about the different factors that shape marine environments. Combine it with a Bachelor of Design and Technology for that tech edge!
The University of Western Australia offers this degree with a minor in ocean innovations, so you can learn how to use tech to make our oceans more sustainable. Talk about making a real difference to the planet!
Bachelor of Science (Technology)
University of Waikato
Bachelor of Biodiversity and Conservation / Bachelor of Engineering (Honours), Macquarie University
Bachelor of Science (Ocean and Climate Sciences) /
Bachelor of Design and Technology, Flinders University
Bachelor of Science (Oceanography), University of Otago
Bachelor of Environmental Engineering,
University of Western Australia
TECHNOLOGY + OCEANS + JOBS
Oceanographer $70K–$80K / NZ$55K–NZ$75K
Robotics technician $60K–$105K / NZ$49K–NZ$80K
Marine mechanic $60K–$80K / NZ$52K–NZ$158K
Electronics technician $50K–$88K / NZ$43K–NZ$74K*
*Salaries according to payscale.com and salaryexpert.com
Anew industry that’s taking off around the world is about to explode in Australia and Aotearoa New Zealand, and it’s already hoovering up every talented tech body it can find: offshore wind.
Dozens of proposed offshore wind farms are currently in the pipeline across Australia. Along with a NZ$4 billion project to build a 65-turbine facility off New Zealand’s Taranaki coast. But there is a problem: the labour shortage in the renewable energy sector. That means there’s huge scope for a new cohort of graduates to join an industry with truly global legs – almost all the offshore wind companies are international.
All kinds of people will be needed, from naval architects right through to sea captains, but some of the most interesting jobs will be in tech: think underwater drone operators and animators who can bring undersea maps to life.
“Spatial data technologies will be important for ongoing environmental assessments, while programmers and developers who have skills in virtual and augmented reality will be critical in developing the technology that can assist with maintenance for offshore wind,” says Carolyn
Software developers, programmers and data managers are in demand as people who can develop digital twin models of offshore wind farms, or design machine learning algorithms so they can be controlled remotely. People who understand data and data security will also be important as the national security of energy generation becomes more critical.
Skilled drone operators and those who can use geospatial technologies such as GIS mapping will also be essential — figuring out the logistics of getting an almost 300m tall turbine from port to its new home in the ocean is not a job for the faint-hearted.
And then there are the sustainability professionals who will ensure the carbon footprint of offshore wind farms is as low as possible, using every AI and tech tool available to reduce waste and ensure ethical sourcing of equipment and materials. –
 RachelWilliamson
RachelWilliamson
virtual and augmented reality skills will be critical”Sanders, head of operations at Flotation Energy, a UK company that’s getting set up in Australia.
by Mixing marine science with clever tech, macquarie university is helping sea life to survive

If you’ve ever taken a stroll along the beach or around a harbour, you’ve probably seen seawalls. They help protect shorelines from storm surges and erosion, but can negatively impact marine environments. Enter Living Seawalls, which installs panels onto these structures to create microhabitats for marine life including seaweeds, shellfish and other creatures, and helps protect them from high temperatures and predators.
So how much tech is involved in this work?
Lots, according to Macquarie University’s Professor Melanie Bishop and Associate Professor Katherine Dafforn, co-leaders of Living Seawalls.

“Living Seawalls panels are computer designed, with prototypes initially fabricated using 3D printing,” Melanie explains. “Panels of 10 different designs, mimicking the features of nature, are then cast using a moulding process from eco-blend cement.”

The project also relies on tech for monitoring and evaluation – temperature loggers tell them about the cool microclimates created by the panels, and oxygen probes reveal how the ecological communities on seawalls are modifying ecosystem functions.
“I use water quality probes to investigate changes in water chemistry around our installations,” Katherine adds. “I also use microscopes to survey marine life growing on Living Seawalls and I sample environmental DNA for sequencing, which tells me more about the kinds of bacteria and other microbes on Living Seawalls.”
The team’s research in Sydney Harbour has shown that after one to two years, Living Seawalls support at least 36% more species than unmodified seawalls, with as many as 85 species of invertebrates, seaweeds and fish living and growing on the panels. What a win! – Louise
 Meers
Meers
Melanie and Katherine share their top tips!
“Maths and all sciences can come in handy, especially if you want to keep your options open. Also, you don’t need to be able to dive or even necessarily swim to be a marine scientist – plenty of work is done from the land or from boats.” – Melanie
“Go for it! The world is experiencing environmentalsignificant change and we need more people who are passionate about environmental science to inform how we manage and respond to that change, to protect the Earth for future generations.”
– Katherineassociate professor Katherine Dafforn marine ecologist

Welcome to the tech + business universe –a place where coders help companies stay ahead of the game and startups disrupt entire industries. Get ready to discover how tech gurus are transforming our workplaces, retail, banking and more, and how you can build a career in this exciting space. –
Here are some of the skills you’ll need to score a tech + business job:
✔ Coding
Understanding different programming languages will give you an edge in almost every tech job.
✔ Data analysis
The ability to make sense of numbers and trends is a huge asset for businesses looking to make smarter decisions.
✔ Creativity
Your ability to think outside the box will help you find the best tech solutions to all sorts of business challenges.
✔ Problemsolving
Every challenge is a new puzzle to solve!
✔ Communication
You’ll need to know how to explain your tech tricks to non-tech folks.
Gemma ChiltonWho’s hiring?
Here’s where you might land a job using your tech + biz know-how …
Think Google, Atlassian, Xero.


Fast-growing companies need tech-savvy minds.
The ‘fintech’ revolution is here!
Online shopping is booming, and retailers need tech experts.
Government
Public services are going digital and employing tech grads.
We’re all used to chatbots on business websites, but now AI-powered natural language models, like the one behind OpenAI’s ChatGPT or Google’s Bard, can be loaded up with specific business or customer info to make them the ultimate customer service pros!
Far from the generic, robotic answers we’re used to getting from old-school chatbots, these will offer personalised assistance, 24/7!

Skill up in AI, machine learning or natural language processing for career opportunities in this area.

Companies collect loads of info about what we like and buy to help improve their sales. This data helps them send us personalised ads that catch our attention – it means more effective advertising for them and fewer irrelevant ads for us.

Data scientists or data analysts are the tech-savvy folks getting paid the big bucks to make sure those ads are totally on-point.

The use of virtual reality (VR) and augmented reality (AR) in retail is growing. ‘Smart mirrors’, for example, use AR to help you mix-and-match new clothes. You can even add cool filters to complete your new look and share it on socials!
VR and AR developers, who usually have computer science or software engineering backgrounds, and user experience designers are the pros behind these immersive shopping experiences of the future.
With digital growth comes digital threats. That means cyber security specialists are now critically important – protecting companies big and small from potential hackers and data breaches. Want sought after tech skills? This pathway should be high on your list.

Heard of Bitcoin? It’s one of many cryptocurrencies that run on blockchain, a technology that keeps track of digital transactions securely. It’s like an unchangeable digital record that’s shared by everyone but controlled by no single person. But blockchain isn’t just for cryptocurrency – businesses are using this technology to track goods, make sure products are legit, and much more.
Skill up in areas like computer science and cryptography to forge a career in this area.
TECHNOLOGY + BUSINESS + STUDY
UNDERGRAD
Bachelor of Information Technology / Bachelor of Business, The University of Newcastle
Bachelor of Business (Information Systems), Auckland University of Technolog y
POSTGRADUATE
Master of Business Information Technology, RMIT
Master of Artificial Intelligence, Victoria University of Wellington
TECHNOLOGY + BUSINESS + JOBS
Business analyst, IT
A$58K–A$123K / NZ$55K–NZ$104K
Business intelligence developer
A$64K–A$133K / NZ$62K–NZ$117K
Cyber security analyst
A$55K–A$121K / NZ$52K–NZ$137K
Machine learning engineer
A$59K–A$149K / NZ$53K–NZ$134K*
*Salaries according to payscale.com
Corey named his company after himself. Yep, Goanna is a nod to his traditional totem and a nickname he was given by one of the elders in his community while he was growing up.

With a 75% success rate for students finding employment after completing their 12-to-24 week courses, Goanna Education is doing something right! Courses give students a kickstart in areas such as data analytics, IT, cloud engineering and programming.
When Corey, a proud Gamilaraay and Dunghutti man, launched Goanna Solutions in 2018, he wanted to break a cycle and make digital technologies, and the skills required to get a job in the field, available to everyone. His motivation? To close the gap on access to the digital world for First Nations people and communities.

Indigenous Australians have been innovating for over 60,000 years, but, “there is a huge underrepresentation of Indigenous people in technology,” Corey says.
Corey’s first foray into tech was tinkering with mobile phones while in high school. After Year 12, he moved to Sydney and tried out a few jobs. But football called and he joined a feeder team to the NRL, based in Newcastle, where the club got him a job in the mines.
It was during a fly-in, fly-out job based in Western Australia’s Pilbara region that Corey began to hatch his plan for Goanna Solutions. Today, the company specialises in IT solutions and support, helping clients with digital integration, data performance and security. It also provides a framework for opportunities in education, training and job success in the STEM arena for Indigenous Australians.
Corey says it’s essential that First Nations people have the opportunity to “learn on Country and earn on Country”. With the expansion into Goanna Education – a new arm of Goanna Solutions (see breakout) – “the sky’s the limit,” Corey says. “You can be anywhere in Australia as long as you’ve got a good connection – and we can help with that!”
Goanna Solutions is a digital company making change and offering training and opportunities for First Nations people
There is a huge underrepresentation of Indigenous people in technology”

They say don’t judge a book by its cover – but if Jane hadn’t picked up a library book when the cover caught her eye 17 years ago, she might not have kickstarted her tech career. The book was about AI and it sparked a flame in Jane that never went out.
After school, Jane completed a Bachelor of Engineering and a Master of Speech Signal Processing at Soochow University in her home country, China. Her fascination with tech then led her across the Pacific to New Zealand, where she completed a PhD in AI at Auckland University of Technology.
Jane then took her expert-level AI qualifications to an Auckland-based tech company called Ambit, which specialises in customer service conversational AI. After starting out as a full stack engineer – helping to develop new features and solve technical issues – she pivoted into her current role as an AI / machine learning engineer.
At Ambit, Jane develops AI solutions to deliver natural, capable and human-like responses to customers. “I use cutting-edge technology to build software that can do tasks automatically,” she explains. For example, she
improves the ability of conversational AI to answer customer questions quickly and accurately.
Jane is excited by the rapid growth of AI, and the opportunities that generative AI and large language models (LLMs) bring to the company and its products.
“We’re seeing a surge in new careers that focus on harnessing the power of generative AI to automate tasks traditionally done by humans,” she says. For example, ‘prompt engineers’, skilled in both tech and language, are next-gen experts at crafting and optimising text prompts for LLMs to achieve desired outcomes.
Jane’s advice to young people interested in a tech career? Find your own passion, pursue it and “don’t give up if there are road blocks along the way”.
– Gemma ChiltonI use technology to build software that can do tasks automatically”Bachelor of Engineering, Soochow University Master of Speech Signal Processing, Soochow University Project engineer, Curative Medical Technology PhD in AI, Auckland University of Technology Full stack engineer, Ambit AI/Machine learning engineer, Ambit Jane Shen
Australian researchers, scientists and engineers are leading the way in tech health, pioneering groundbreaking creations like the multi-channel Cochlear ear implant, spray-on skin and needle-free vaccine technology Our impressive track record of innovation in medical tech is transforming countless lives worldwide.
The need for all kinds of tech solutions in health and medicine means there’s serious growth in this field. As life expectancies grow – along with demand for a higher quality of life – the medical technology sector is booming. In Australia, it’s estimated to be worth $6.1 billion, with the

Health Engine, a consumer healthcare platform used by over 13 million people, helps patients connect with healthcare providers and make appointments online. It allows patients to access more timely appointments thanks to real-time info on appointment availability, plus it allows users to book 24/7.


potential to create 28,000 new jobs by 2025 – great news if you want a career that has a real impact!
From state-of-the-art medical devices to cutting-edge digital platforms, healthcare systems are undergoing a huge technological evolution, improving patient care, diagnosis and treatment.

So, if using state-of-the-art medical technology, solving complex healthcare challenges and saving lives sounds like something you’d love to do, a rewarding career in tech health awaits you. Embark on a journey to shape the future of healthcare for generations to come! – Danielle
LucasEmpowering health through tech is your gateway to an impactful career
These problem-solvers use cool gadgets and high-tech machines to analyse patient samples and help doctors make accurate diagnoses. Their work ensures we get the most suitable treatments.
Biomedical engineers use advanced tech including robots and nanotechnology to analyse medical problems and design solutions like artificial organs, revolutionary drugs and the camera pill.

Specialist techniques and equipment such as the Da Vinci Xi surgical robot help these experts to perform minimally invasive surgeries that improve results and reduce a patient’s risk of infection and recovery time.

As a health data scientist, you’ll manage and analyse healthcare data to identify patterns, predict diseases and help find solutions to the world’s health challenges.
Research, develop and test innovations, like new drugs and medical technologies, that are designed to improve medical practices and enhance our lives.


This cool branch of therapy uses virtual reality to deliver immersive experiences that can help people with phobias, PTSD and pain management.
Bachelor of Information and Communications Technology (Health Information Management), Western Sydney University
Bachelor of Medical Sciences / Bachelor of Cognitive and Brain Sciences, Macquarie University
Bachelor of Engineering (Medical) (Honours), QUT
Bachelor of Engineering (Biomedical Engineering), University of Auckland
Bachelor of Molecular Sciences / Master of Bioinformatics, University of WA TECHNOLOGY + HEALTH + JOBS Research assistant, medical $57K–$84K / NZ$39K-NZ$52K Software developer $54K–$107K / NZ$52K-NZ$99k
Medical technologist $56K–$92K / NZ$55K-NZ$65K
Biomedical engineer $57K–$96K / NZ$66k-NZ$108K*
*Salaries according to payscale.com

Kelly is a passionate researcher driven by a desire to make a difference. She stands at the forefront of technology and research, using her STEM expertise to tackle human communication problems related to hearing loss.

Kelly’s research aims to identify markers that signal when someone is having a hard time communicating – things like heart rate or even body movements in noisy environments.
“We then think about what we can do with that information to ease communication,” she says. “If you have a hearing device, perhaps we can adjust the technology to better adapt to that environment.”
As we age, hearing loss affects communication and social interaction, so this technology can help improve an individual’s quality of life.
Kelly’s journey into this field began after she developed a language disorder following a stroke.
“When I was lying in the ICU, I was thinking about how people communicate, because I couldn’t talk, read or write at the time,” she explains. “It isn’t just about speech, it’s so much more than that. My own
difficulties really inspired me to contribute in this research area.”
One of the most interesting findings from her research is that in noisy environments, people unconsciously sync their movements during communication.
“In fact, there’s growing research showing how our brains, heartbeats, and even our eyes start to sync up — how cool is that?”
For Kelly, collaborating with professionals from other disciplines, including industry partners like Google (Research) and Cochlear, is a real highlight of her work. “Coming together to solve these big scientific problems with people from different fields really pushes the boundaries of innovation,” she says. –
Danielle LucasComing together with people from different fields really pushes the boundaries of innovation”
dr kelly miles hearing researcherBachelor of Speech and Hearing Sciences (Honours), Macquarie University Research assistant, Child Language Lab, Macquarie University Postdoctoral research fellow, ECHO Lab, Macquarie University Research fellow, ECHO Lab, Macquarie University

Lauren once thought that studying psychology could only lead to a job as a clinical psychologist. Now, she’s forging a unique career that combines psychology with… quantum physics!


Lauren is part of a QUT research group looking at quantum cognition. “This involves borrowing concepts from quantum physics and using them to explain how we as humans make decisions,” she explains. “In quantum physics, tiny particles behave weirdly and irrationally, and humans tend to behave weirdly and irrationally as well!”
Specific areas she applies this research to are human trust judgements, including first impressions, and interactions with information and technology. If that doesn’t keep her busy enough, Lauren is also an associate lecturer in QUT’s Master of IT program. Here, she uses her psychology background to help students understand why we have technology and how we use it.
Lauren has had a super varied career, having also worked in user experience consulting and on projects looking at the use of virtual reality for neurodiverse people.
She’s even taken part in NASA design challenges (and won), founded a space startup and co-designed an app to help mental health professionals streamline their reporting.
Her advice to high school students considering a tech career is to follow your passions — they might lead you to a job that doesn’t even exist yet — and to not limit yourself to one idea of what a career should look like.
“I never would have thought that I’d be involved in engineering or a detailed scientific field because I didn’t like maths in high school,” she says. “But you might just not like something now because you haven’t been able to apply it to something that you’re really interested in.” – Louise Meers
i didn’t like maths in high school”
Equal parts artistic and digitally savvy? Create yourself an arts-focussed tech role

With the Australian Government committed to having 1.2 million tech jobs by 2030, you can bet there’s a palette full of creative digital gigs up for grabs in everything from fashion and gaming to retail, banking and music production.
Next-gen creatives are gearing up with skills like coding, AI, app development, user experience (UX) design and virtual reality (VR). Even in straight-up tech roles, creativity is as much an asset as advanced IT skills. And it’s the same deal in Aotearoa New Zealand too, with local skills shortages
canvas
Chances are there’s a tech career to match your creative passion
Art
User interface (UI) designer
Music
Audio engineer
Fashion
eCommerce manager

Film Virtual reality storyteller
Gaming
3D animator Writing Digital editor
making computer science professionals some of the most highly paid and sought after in the country.
“Just because you’re good at one subject, doesn’t mean that’s it,” stresses NZ-based teacher-turned innovation specialist Jessie Robieson, who believes there should be an ‘A’ for art in STEM! “We wouldn’t have something as cool as molecular gastronomy, for example, if no one had made the link between cooking and science!”
Creative tech roles are embracing grads that can flex both sides of their brains – and for double the job opportunities.
“So many teachers don’t see the interconnectivity [between different subjects],” Jessie says. “But there are so many careers out there with a mix of many!”
In fashion, brands are employing designers who double as machine learning engineers.

Lee and tech go way back. The VET grad has worked in IT support for over 20 years, servicing the public and private sectors in Aotearoa New Zealand.
Equal parts into computers, design and the creative art of storytelling, Lee has jumped from IT engineer to analyst to filmmaker. Most recently, he combined all his talents to found Arataki Systems, a Māori-owned tech solutions company.
“I’m incredibly passionate about Māori storytelling and the importance it holds for our future generations in terms of the transfer of knowledge, the continuation of our narratives and the retention and maintenance of our culture,” he says.

Lee’s latest project allows users to access authentic cultural content around NZ via a proximity-based app. And, as a proponent of diversity in tech, all the mahi (work) he does at Te Matarau — The Māori Tech Association — is dedicated to increasing wider cultural representation in local STEM sectors.
In animation, coding and VR are becoming just as important as slick sketching skills. Even banks are looking for creative tech minds, with the teams behind their digital releases and apps skilled in user interface (UI) design and product development.
The best thing about creative tech careers is that study pathways are a blank canvas! Pick your specialisation (IT support! UX design! Software engineering! AI! VR!) or enrol in a Bachelor of Computer Science and find your way from there.
Get a headstart in high school with free resources like Codestar, or join a hackathon to use your creativity and STEM skills in a fun and collaborative way.
And again, if you’re worried about landing a job – don’t be! Everyone from The Iconic to Animal Logic, Atlassian, CommBank, Canva and Universal Music are seeking out tech grads for their creative teams. Yep, your tech career can be a work of art. –CassieSteel
Bachelor of Computer Science, RMIT
Bachelor of Information
Technology (Virtual Reality), Deakin University
Diploma of Information Technology, TAFE NSW
Bachelor of Design (Visual Effects and Game Design) Auckland University of Technology
Bachelor of Audio Engineering and Production, Southern Institute of Technology
3D animator A$40K–A$83K / NZ$48K–$94K
UX designer A$54K–A$111K / NZ$49K–NZ$114K
Web designer A$43K–A$93K / NZ$42K–NZ$123K
Audio engineer A$43K–A$94K / NZ$47K–NZ$84K
Lighting designer A$55K–A$94K / NZ$42K–NZ$88K*
*Salaries according to payscale.com
ZAHN TROTTER, SMOKE PHOTOGRAPHY Diploma of 3D computer animation, Media Design School Service desk manager, StreamCom IT support engineer, AVC group MorphDirector,Creative CEO and founder, Arataki Systems CEO, Te Matarau - the Māori Tech AssociationJ. Rosenbaum figured out how to combine their passion for creativity with their love for tech and now teaches others how to tap into that vision

Watching fantasy novels and sci-fi movies with their dad got J excited about how digital figures came to life.
“We’d watch shows and then we’d talk about them and analyse them. Stories about AI really got me going,” J recalls. But they credit their mum and granny for introducing them to art.
“My mum fed absolutely every one of my crazy hobbies,” J says. “It might’ve been getting me a chemistry textbook one week or new art supplies. She always gave me time to explore new and different things.”
Now, their love for creating interesting things has come full circle. “I’m very lucky. My granny was an artist; she was a sculptor and later a painter and she loved art. I can’t believe that I learnt the techniques I’m using now from Granny. She taught me about sculpting techniques that we use on lost wax [lost-wax process is a metal casting method].
Sculpting is like the earliest form of modelling, just with our hands,” they say.
It’s a pretty cool legacy, but J hasn’t always been the artist they are today.
“I did about 50 different things after school,” they joke. “I started doing a Bachelor of Archeology, then philosophy and some programming. I wanted to learn everything. Then I got enticed by the dot.com boom and ended up not finishing my bachelor’s degree.”
Instead, J took a break from uni and started building websites, working in web design and doing project management before a car accident left them with a permanent disability that meant they couldn’t work behind a desk anymore. The silver lining? J started painting again.
“I always loved painting and making art and when I went into the web world, I felt like I stopped being creative,” J says. “So when I rediscovered art, everything kind of became full colour again.”
I discovered I could work with code and still be creative and make art”
“That’s the exciting thing about the AI stuff: I discovered I could work with code and still be creative and make art. Plus, my project management skills have come in very handy with managing larger projects and print work,” they say.
J enrolled in a Master of Contemporary Art, majoring in visual art, at the Victorian College of the Arts, and it was during this study that the creative combo of art and tech really clicked for them. “My first image was absolutely hideous, but it created something and from there an artwork started to emerge. I pivoted from painting at the beginning of my master’s to the 3D and then to bringing in the AI and augmented reality (AR) and all these
really cool technologies because that’s where my heart was,” J says.
J exhibits their own work both virtually and IRL now. Recently, they completed their PhD in art at RMIT, where they now lecture part time.

“I love teaching,” J says. “I’m teaching about critical AI and those tools: how to use them, what to use, why… and I talk a lot about transparency, because we need transparency in AI.”
J’s advice for those who want to combine their love of creativity with STEM? “Science, technology, engineering and maths… they’re everywhere. Think about what brings you joy, and make whatever gives you passion and excitement.”
– Pippa DuffyFrom bushfires to floods, tsunamis and earthquakes, Australia and Aotearoa New Zealand see their fair share of natural disasters. And as climate change cranks up the intensity of many of these events, how well we cope often boils down to how well we predict, prepare for and respond to them.
Enter the tech heroes – skilled problem-solvers using the power of STEM to make our world safer. These are the folks creating apps to keep the public informed during bushfires, inventing wearable
tech to keep first responders safe and developing smart AI that can predict disasters and help us get through them.
Interested in joining this important mission? One way you could kick off your journey is with a tech degree that offers majors related to disaster management – or you could pursue a postgraduate course in this area. Along the way, remember to beef up your resume with relevant internships or experiences such as student-led projects and STEM competitions. – Gemma Chilton
Inspired by heroic first responders, but looking for tech pathways? Explore these tech gigs that help us predict, manage and recover from natural disasters.

2 1
FIRST RESPONDERS: Firefighters from organisations like the NSW Rural Fire Service or Fire and Emergency New Zealand combat the blaze and protect people and property.
TECH RESPONDERS:
• Data scientists help figure out where fires might happen next by studying everything from weather patterns to plant types and previous fires.
• GIS specialists use geographic information systems (GIS) – computer mapping systems – to guide firefighters in the (literal) heat of the moment.
• Software engineers build apps to keep people informed and safe during bushfires.

FIRST RESPONDERS: Emergency workers from the State Emergency Service in Australia or NZ’s Civil Defence help to evacuate people and mitigate flood damage.
TECH RESPONDERS:
• Data analysts look at weather and water data to predict when floods might happen.

• Full stack developers design computer tools to help prepare for floods.
• Remote sensing specialists use aerial images to monitor flood progression and assess damage.
3
FIRST RESPONDERS: Organisations like the Queensland Fire and Emergency Services or NZ’s Rescue Coordination Centre provide immediate aid and support in the affected areas.
TECH RESPONDERS:
• Data scientists use weather data to predict when and where cyclones might happen.


• Web developers create websites that show where cyclones are moving.
• User experience (UX) designers make sure warning apps are easy to use.
UNDERGRAD
Diploma in Arts (Emergency Management), Massey University
Bachelor of Emergency Management, Charles Sturt University
POSTGRAD Graduate Certificate in Emergency and Disaster Management, QUT
Earthquakes
FIRST RESPONDERS: Urban Search and Rescue teams find and help victims trapped in rubble.

TECH RESPONDERS:
• Data analysts look at ground-shaking data to help guess when earthquakes might happen.
• Software engineers create computer simulations that pretend to shake buildings in a virtual environment to test if they’re safe.

• Network engineers work on phone and internet systems so they keep operating during earthquakes.
5
4 Tsunamis
FIRST RESPONDERS: Rescue teams from the Australian Maritime Safety Authority or NZ’s National Emergency Management Agency provide aid, evacuate people and initiate clean-up efforts.
TECH RESPONDERS:
• Data analysts use sea-level data and seismic activity to predict potential tsunamis.
• Software engineers develop early warning systems for tsunamis.
• Network engineers ensure communication networks remain operational during and after a tsunami event.
Here’s where you might land a job using your tech know-how to help during times of disaster:
• Government and public agencies (e.g. the Australian Bureau of Meteorology or Fire and Emergency New Zealand)
• Non-profit organisations (e.g. the Australian Red Cross or the World Wildlife Fund)
• Universities and research institutions (e.g. CSIRO)
• Private companies and startups (e.g. the Google Crisis Response team)
Master of Disaster Resilience and Sustainable Development, The University of Newcastle
TECHNOLOGY + DISASTER RESPONSE + JOBS
Data analyst
A$56K–A$111K / NZ$50K–NZ$90K
Full stack software developer A$57K–A$124K / NZ$51K–NZ$108K
Network engineer A$55K–A$126K / NZ$50K–NZ$103K
UX designer A$56K–A$113K / NZ$51K–NZ$113K*
*Salaries according to payscale.com
Tiarna had her eureka moment during a visit to a fire station on her 15th birthday. The biggest threat to firefighters, she learnt, was not smoke inhalation or burns, but overexertion and stress. Shocked to discover there was no real-time system to monitor this risk, Tiarna put her high school STEM smarts to use and invented IntelVest to safeguard our heroes.
Since rebranded to Oxersense, Tiarna’s brainchild is a sleek, sensor-packed gadget that tucks into firefighters’ gear. It tracks health vitals and environmental info, and communicates this data to an outside team that can act fast if a firefighter is in danger.

“It’s incredible to think that the technology we are developing at Oxersense can potentially save lives by protecting those who protect us,” Tiarna says. “Building this company from its inception and seeing it grow into a tool for safety is both rewarding and exciting.”
After school, Tiarna started an advanced science degree at The University of Queensland, majoring in genetics and biochemistry.
Balancing uni and Oxersense is challenging, but Tiarna’s all-in. Her days are filled with lectures and lab work, and meeting with firefighters and pitching for funding.

As well as being recognised with several awards, Oxersense won a spot in the UQ
Ventures ilab Accelerator program, which will help launch her invention into the real world. Away from academia and startups, Tiarna likes to kickback with 3D art.
“The creativity and technical precision involved in 3D modelling is a fantastic counterbalance to my studies and business management duties,” she says.
With a promising future in genetics and biology, Tiarna’s excited about where her studies might lead. “The future of medicine lies in our genetic code, and we’re just beginning to unlock its potential,” she says.
Her advice to others? Stay curious, embrace failures and grab every opportunity. “You never know where it could lead.” – Gemma
Chilton Tiarna McElligott, the student-CEO who’s saving firefighters with wearable techbuilding this company is both rewarding and exciting”Founder and CEO, Oxersense Bachelor of Advanced Science (Honours), The University of Queensland SHUTTERSTOCK
Do you have what it takes to teach yourself a new programming language? Take our quiz to find out!
Your alarm goes off at 7am and you have to be ready to leave the house by 8am. You:
a. Hit the snooze button and keep hitting it until 7.50am and then get ready in a flash.
b. Jump out of bed and grab the clothes I already laid out the night before so I have plenty of time for breakfast.
c. Get up at 7.15am and get ready, then watch YouTube while having breakfast and chatting to my friends on Snapchat.
Your friends would describe you as…
a. Easily distracted
b. Patient
c. Determined
What’s your work ethic?
a. I do the minimum I need to do to get by.
b. I like to have a stable work or school/life balance, but I’m not afraid to work hard.
c. When I’m not at work or school, I’m always working on my passion project.
Hmm… not so much
Never say never, but it sounds like you might find it hard to stay motivated and spend the hours required to learn to code by yourself. Having a structured class with a teacher and deadlines would probably be a better option for you.
Mostly Bs
Learning basic code is relatively simple and you may have already done it at school. For this quiz, we’re talking about learning a coding language like JavaScript, PHP or Python. Learning one of these will take three to nine months depending on how much time you devote to it. – Charis Palmer
a. Being outdoors a lot
b. Working with numbers
c. Learning about new technologies and building cool things with them
Which of these TV shows would you watch/prefer?
a. Silicon Valley
b. Mr Robot
c. Halt and Catch Fire
Decide what you want to build
You’ll be far more motivated if you have an end point in sight.
Start small
Pick a programming language that aligns with the type of thing you’d like to build, whether it’s an app, a game or something simpler.
Do some more research
It sounds like you could teach yourself to code, but you might want to do a bit more reading about what’s involved and see if you can fit it into your current schedule.
Mostly Cs
Start coding now!
You’re self-disciplined and likely to find the time to learn something you enjoy.
There are lots of free resources available online, such as the free options on Udemy or The Odin Project consistency is key Set yourself a goal, like ‘one hour of learning a day’, and don’t forget to reward yourself when you get to the end of a month of effort!
1Which career from this magazine would you love to have?
2Which ‘X’ (passion, hobby, interest or other area) is your favourite?
Oceans Cyber security
Health Creativity
Business Robotics & AI
Disasters
3Can’t decide? Scan the QR code to take our fun ‘What’s your STEM + X’ quiz!
Alejandro Davila, virtual reality (VR) storyteller
Alejandro is the founder of Conical Studios, a video game and animation company based in Auckland. He was the first VR movie producer in New Zealand and adapted his thesis project, The Green Fairy, into a VR movie, children’s book, TV series and video game!


Careers with STEM: Technology 2023 is a publication and trademark of Refraction Media. Copyright © 2023 Refraction Media, all rights reserved. No part of this publication may be reproduced in any manner or form without written permission. If you would like to reproduce anything from this magazine, email: info@refractionmedia.com.au.
We acknowledge the Traditional Owners of country throughout Australia and recognise their continuing connection to land, waters and culture. We pay our respects to their Elders past, present and emerging.
This issue went to press on 5 October 2023.
Printed in Australia by IVE.
Cover image: Lauren Trompp
4Which tech company would you like to work for? (Read more about them on pages 10-11)
Australia
Google Atlassian
Canva Telstra
Afterpay
New Zealand
Xero Halter
Ambit Serato
Cogo
5Whose career would you like to hear more about? (Scan their QR code!)




Punahamoa ‘Puna’ Walker, AI researcher
Puna is a researcher for FranklyAI, a Kiwi chatbotlike platform that can speak Te Reo Māori and its iwi (tribal) dialects. It’s used by governments, universities and other organisations to consult with students, customers and the public.
Make notes about what you can do next to help your future tech career. That might be having a chat with your career advisor, exploring TAFE and uni options, teaching yourself to code or heading to CareerswithSTEM.com to check out more awesome jobs.
Produced and published by: Refraction Media
Co-founder, CEO & Publisher : Karen Taylor-Brown
Co-founder, CEO & Head of Content: Heather Catchpole
Managing Editor: Charis Palmer
Digital Content Strategist: Louise Meers
Sub Editor: Amelia Caddy
Art Director: Katherine Power

Writers: Gemma Chilton, Heather Catchpole, Pippa Duffy, Danielle Lucas, Louise Meers, Charis Palmer, Ravisha Rajapaksha, Cassie Steel, Rachel Williamson
SUBSCRIBE AND ORDER COPIES: CareerswithSTEM.com /subscribe
EDITORIAL & ADVERTISING ENQUIRIES: Email: info@refractionmedia.com.au or +612 9188 5459
POSTAL ADDRESS: PO Box 154, Oyster Bay, NSW 2225, Australia
CareerswithSTEM.com ISSN 2209-1076

Niamh Fitzgerald, game developer
Niamh works at Dinosaur Polo Club, which is based in Wellington. She was the lead designer on a game called Mini Motorways, a strategy simulation game about designing the roads of cities around the world while populations grow.

after reading this issue of
Collect your thoughts and ideas on this page!
Years PreK–8 (ages 4–16)
FIRST® LEGO® League introduces students to STEM in a fun and interactive way. Through guided global robotics activities, students gain real-world problem-solving skills and experience. The program’s three divisions inspire students to develop their critical-thinking, coding and design skills through STEM learning and robotics.
Registration open: April – October
Challenge release: August
Event season: October – April
Teams: Up to 10 students for the Challenge division and smaller, age-appropriate teams for the Discover and Explore divisions


Time commitment: 1–3 hour meetings (12 sessions)

FIRST® is the world’s leading youth-serving not-for-profit advancing STEM (science, technology, engineering and maths) education. For more than 30 years, students from all walks of life have developed self-confidence in STEM and valuable, real-world skills through FIRST that open pathways to a better future. Through a suite of team-based robotics challenges and backed by a global network of mentors, coaches, volunteers, alumni and sponsors, FIRST helps young people discover a passion for STEM, and become leaders and innovators in any industry.
Three age-specific programs are offered.
Years 7–12 (ages 12–18)
FIRST® Tech Challenge students learn to think like engineers. Teams design, build and program robots for alliance-based competitions. Robots are built from a reusable Android-powered platform and can be coded using various languages. Participants and alumni enjoy lifelong access to education and career opportunities and a supportive FIRST community.
Registration open: May – April
Game release: September
Event season: October – April
Teams: Up to 15 students
Time commitment: 90-minute to 3-hour meetings, held twice a week for 9–12 weeks
Years 9–12 (ages 14–18)
FIRST® Robotics Competition teams design, program and build industrial-sized robots from scratch with a kit of parts and a common set of rules to play a different game every season. Teams also create a team identity, form community partnerships for support and promote STEM in their local community. Participants and alumni enjoy lifelong access to education and career discovery opportunities and a supportive FIRST community.
Registration Open: May – December
Game Release: January
Event Season: February – April
Teams: Students
Time Commitment: Teams typically meet several times a week, January – April
If you’d like to chat to us about setting up a team in your school, club or local area, please give us a call on (02) 9850 8329 or email to angela.melville@mq.edu.au
Technology is predicted to transform 1.1 billion jobs in the next 10 years. From automation to AI, there’s booming demand for humans with the creativity to design the systems that will keep us connected.
Be ready—with an IT or Games degree from QUT.
Learn how to use information and automation to develop creative solutions for complex problems. With real-world client projects and industry connections, you’ll be ready to forge a career shaping the future of technology.
